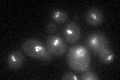
YKR010C

View description
Protein required for rDNA silencing and mitotic rDNA condensation; stimulates Cdc14p phosphatase activity and biphasic release to promote rDNA repeat segregation; required for condensin recruitment to the replication fork barrier site
Localization:
Intensity:
Fold change:
Significance:
-
C’ GFP library in SD
nucleolus24.46 -
N' NOP1pr-GFP in SD

nucleolus48.2496 -
N' TEF2pr-mCherry in SD

nucleus,nucleolus25.394 -
N' NATIVEpr-GFP in SD

punctate,nucleolus24.3787 -
N' TEF2pr-VC and Cyto-VN in SD

mitochondria27.3462 -
C’ GFP library in SD+DTT

nucleolus21.720.88No -
C’ GFP library in SD+H2O2

nucleolus24.240.99No -
C’ GFP library in Starvation Media

nucleolus21.240.86No -
C’ GFP library on the background of Pup2-DaMP

nucleolus -
C’ GFP library on the background of CCT mutant

nucleolus23.84470.97435No
